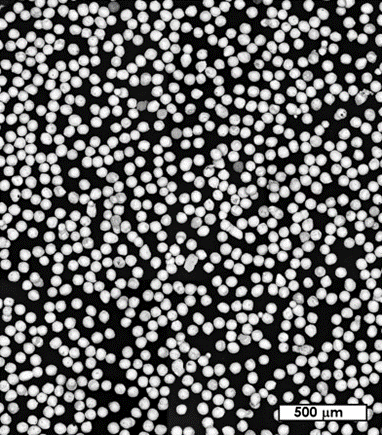
This electron microscope image shows spherical bismuth powder. Each particle in the photo is about the diameter of a human hair (approximately 60 micrometers).

To Advance Cancer Therapy, University Starts Producing Terbium-161
A University of Utah research team demonstrates that a low power university research reactor can produce terbium-161 at high purity from gadolinium-160.

A University of Utah research team demonstrates that a low power university research reactor can produce terbium-161 at high purity from gadolinium-160.

Researchers explore the effects of radiation and harsh chemicals to optimize americium-241 production.

Researchers gain new insights into a strong bond between the isotope astatine-211 and common chemicals, creating new possibilities for cancer treatment.

Scientists have developed tiny nanocrystal particles made up of isotopes of the elements lanthanum, vanadium, and oxygen for use in treating cancer.

Scientists characterize a promethium coordination complex for the first time, furthering the understanding of difficult-to-study lanthanide elements.

Scientists investigate the adsorption, thermodynamics, and kinetic properties of terbium on two popular resins for lanthanide separations: DGA and LN.

Researchers developed a remotely controlled device for the safe and efficient purification of astatine using liquid phase chemistry.
Free-flowing metal powders offer improvements for additive manufacturing, isotope production target fabrication, and more.

Researchers develop a framework to predict subcooled flow boiling and critical heat flux.

Researchers gain new insights into how the isotope astatine-211 interacts with resins commonly used to purify the isotope for therapeutic use.

Researchers used single crystal X-ray diffraction to learn about the structure and bonding of a highly radioactive radium compound.

Researchers advance the use of cerium/lanthanum-134 for medical scans in actinium-225 cancer therapy.